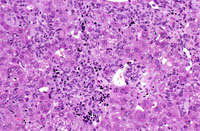
Histiocytic Sarcoma
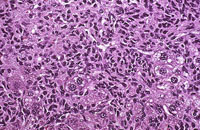
Histiocytic Sarcoma

The Digitized Atlas of Mouse Liver Lesions

Much of the work carried out by DTT is in support of the National Toxicology Program (NTP), an interagency partnership of the Food and Drug Administration, National Institute for Occupational Safety and Health, and NIEHS.
Visit the NTP WebsiteHistiocytic sarcoma (Kupffer cell sarcoma) is a multicentric neoplasm of mice that frequently involves the liver. It is uncertain whether the cells are derived from Kupffer cells or from other histiocytes. The malignant cells grow along the sinusoids and vessels, efface the normal architecture of the hepatic lobules, and sometimes form nodules.
Spontaneous histiocytic sarcomas occur at low frequency in mice. Histiocytic sarcomas may simultaneously occur in other organs such as the spleen, lung, and uterus and are regarded as systemic neoplasms.
Extensive hepatic involvement by malignant histiocytic cells.
Low and high magnifications of a histiocytic sarcoma with a nodular growth pattern in the liver.
Giant cell formation in a histiocytic sarcoma.